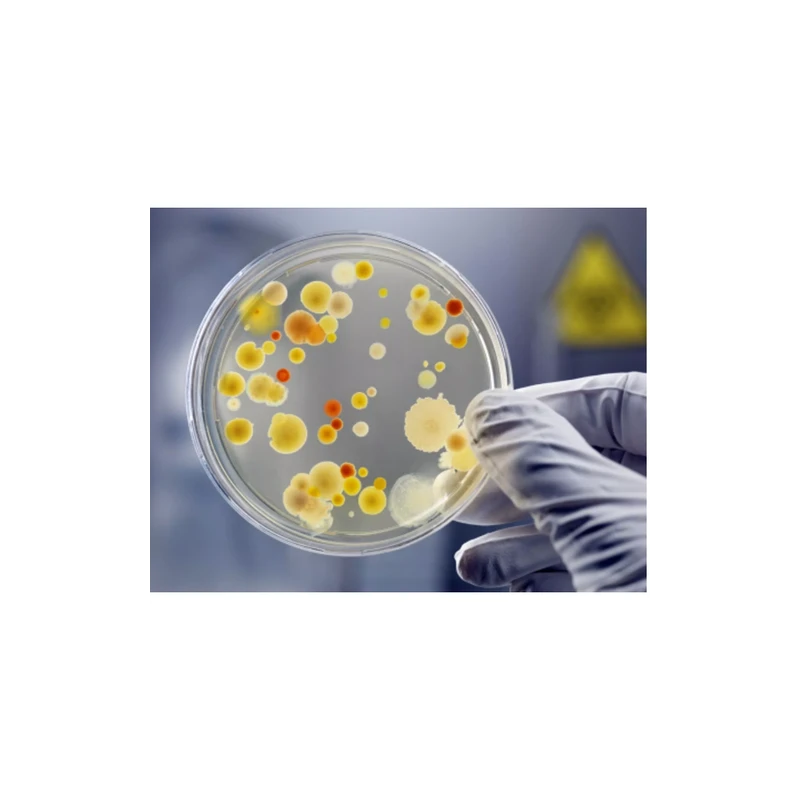
bacteria-culture-10207
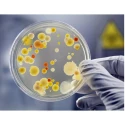
bacteria-culture-10207
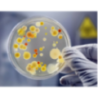
Bio-Tech Grade Bacteria Culture

$3.44
($3.44 per sample)
Tax included
×
Product Enquiry
Bio-Tech Grade Bacteria Culture

Comments (0)
Your review appreciation cannot be sent
Report comment
Report sent
Your report cannot be sent